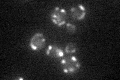

View description
Mitochondrial beta-keto-acyl synthase with possible role in fatty acid synthesis; required for mitochondrial respiration
Localization:
Intensity:
Fold change:
Significance:
-
C’ GFP library in SD

mitochondria28.38 -
N' NOP1pr-GFP in SD

ER34.4314 -
N' TEF2pr-mCherry in SD

missing0 -
N' NATIVEpr-GFP in SD

below threshold17.6947 -
N' TEF2pr-VC and Cyto-VN in SD

#N/A0 -
C’ GFP library in SD+DTT

mitochondria29.161.02No -
C’ GFP library in SD+H2O2

mitochondria24.920.87No -
C’ GFP library in Starvation Media
mitochondria33.321.17No -
C’ GFP library on the background of Pup2-DaMP

mitochondria -
C’ GFP library on the background of CCT mutant

mitochondria31.051.09355No
